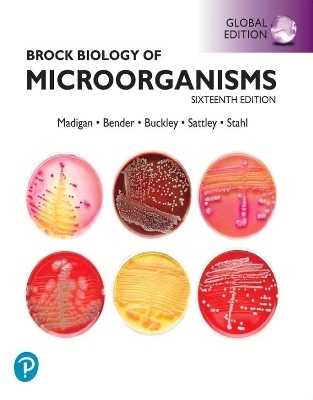
Brock Biology of Microorganisms, Global Edition plus Mastering Biology with Pearson eText - Michael Madigan, Jennifer Aiyer, Daniel Buckley, W. Sattley, David Stahl

Brock Biology of Microorganisms, Global Edition plus Mastering Biology with Pearson eText
Pearson Education Limited
978-1-292-73156-8 (ISBN)
The text guides you through the six major themes of microbiology — Evolution, Cell Structure and Function, Metabolic Pathways, Information Flow and Genetics, Microbial Systems, and the Impact of Microorganisms — as outlined by the American Society for Microbiology Conference on Undergraduate Education (ASMCUE).
Following a modern robust approach, the book supports your knowledge of the genomics and other omics" maze - concepts that are fundamental to the field and have transformed and revolutionised microbiology. Furthermore, it provides concrete examples of how powerful tools have allowed microbiologists to probe deeper and further into the microbial world than ever before.
Michael T. Madigan has taught courses in introductory Microbiology and Bacterial Diversity for 33 years as a Professor of Microbiology at the Southern Illinois University Carbondale. Mike's research focuses on phototrophic bacteria that inhabit extreme environments, and for the past 20 years, his emphasis has been Antarcticmicrobiology. Kelly S. Bender is' an Associate Professor at Southern Illinois University Carbondale and has served as Chair of the SIUC Department of Microbiology since 2018. Kelly teaches courses in introductory Microbiology and Microbial Diversity, and her lab studies a range of topics, including regulation of sulphate-reducing bacteria and the microbial community dynamics of sites impacted by acid mine drainage. Daniel H. Buckley is a Professor at Cornell University in the School of Integrative Plant Science and the Department of Microbiology. He has taught both introductory and advanced courses in Microbiology, Microbial Diversity, and Microbial Genomics. He currently serves on the editorial boards of Applied and Environmental Microbiology and Environmental Microbiology. Matthew Sattleyis a Professor of Biology at the Division of Natural Sciences, Indiana Wesleyan University (IWU), and has served as the Director of the Hodson Summer Research Institute, a faculty-led summer research program for undergraduate students in the Natural Sciences. Matt’s research group investigates the ecology, diversity, and genomics of bacteria that inhabit extreme environments. David A. Stahl is a Professor in the Departments of Civil and Environmental Engineering and M
UNIT 1: THE FOUNDATIONS OF MICROBIOLOGY
The Microbial World
Microbial Cell Structure and Function
Microbial Metabolism
Microbial Growth and Its Control
Viruses and Their Multiplication
UNIT 2: MOLECULAR BIOLOGY AND GENETICS
Microbial Information Flow and Protein Processing
Microbial Regulatory Systems
Molecular Aspects of Microbial Growth
Genetics of Bacteria and Archaea
UNIT 3: GENOMICS, SYNTHETIC BIOLOGY, AND EVOLUTION
Microbial Genomics and Other Omics
Viral Genomics and Diversity
Biotechnology and Synthetic Biology
Microbial Evolution and Genome Dynamics
UNIT 4: MICROBIAL DIVERSITY
Metabolic Diversity of Microorganisms
Ecological Diversity of Bacteria
Phylogenetic Diversity of Bacteria
Phylogenetic Diversity of Archaea
Diversity of Microbial Eukarya
UNIT 5: MICROBIAL ECOLOGY AND ENVIRONMENTAL MICROBIOLOGY
Taking the Measure of Microbial Systems
Microbial Ecosystems
Nutrient Cycles
Microbiology of the Built Environment
Microbial Symbioses with Microbes, Plants, and Animals
UNIT 6: MICROBE – HUMAN INTERACTIONS AND THE IMMUNE SYSTEM
Microbial Symbioses with Humans
Microbial Infection and Pathogenesis
Innate Immunity: Broadly Specific Host Defenses
Adaptive Immunity: Highly Specific Host Defenses
Immune Disorders and Antimicrobial Therapy
UNIT 7: INFECTIOUS DISEASES
Diagnosing Infectious Diseases
Epidemiology and Public Health
Person-to-Person Bacterial and Viral Diseases
Vectorborne and Soilborne Bacterial and Viral Diseases
Waterborne and Foodborne Bacterial and Viral Diseases
Eukaryotic Pathogens: Fungi, Protozoa, and Helminths
| Erscheint lt. Verlag | 15.2.2024 |
|---|---|
| Verlagsort | Harlow |
| Sprache | englisch |
| Maße | 247 x 277 mm |
| Gewicht | 2783 g |
| Themenwelt | Naturwissenschaften ► Biologie ► Mikrobiologie / Immunologie |
| ISBN-10 | 1-292-73156-7 / 1292731567 |
| ISBN-13 | 978-1-292-73156-8 / 9781292731568 |
| Zustand | Neuware |
| Informationen gemäß Produktsicherheitsverordnung (GPSR) | |
| Haben Sie eine Frage zum Produkt? |